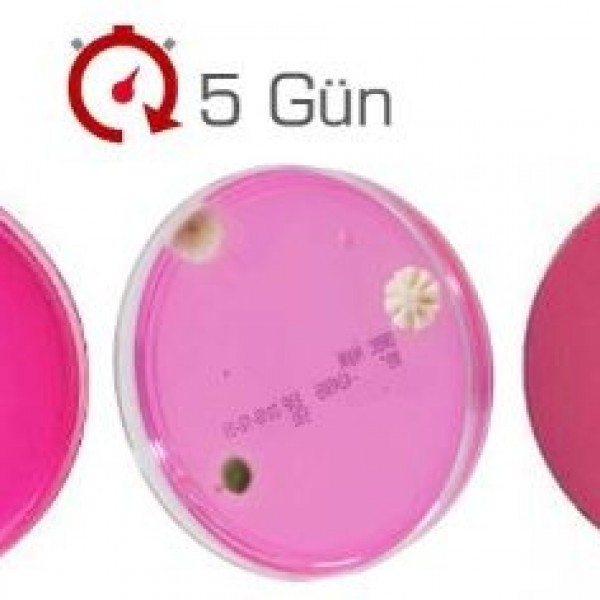

- HOME
- OUR SERVICES
- Laboratory Equipment and Chemicals
- Hazır Besiyerleri
- DRBC Agar (Küf - Maya Sayımı)
DRBC Agar (Küf - Maya Sayımı)
DRBC Agar (Mold - Yeast Count)
DRBC Agar (Mold - Yeast Count)
DICHLORAN ROSE BENGAL CHLORAMPHENICOL AGAR
In standard microbiological analyzes performed in vitro (outside of living cells), yeast and
It is used as a selective solid medium for growth and enumeration of molds.
Our Services
- Detection Kits
- Laboratory Equipment and Chemicals
- Şişe Üstü Dispenserler
- Rotary Evaparator
- Çalkalayıcılar
- Kuru Blok Isıtıcı
- Vorteksler
- Viskozimetreler
- Teraziler
- Nem Tayin Cihazları
- Ph-İletkenlik-Çözünmüş Oksijen
- Elektrodlar
- Titratörler
- Refraktometreler
- NIR Analiz Cihazları-(Near Infrared)
- SpectraAlyzer FOOD/Gıda analizleri için
- SpectraAlyzer FLOUR/Un analizleri için
- SpectraAlyzer DAIRY/Süt ürünleri analizleri için
- SpectraAlyzer WINE&SPIRITS/Şarap ve alkollü içki analizleri için
- SpectraAlyzer BRAUMEISTER/Bira analizleri için
- SpectraAlyzer OLIVE/Zeytinyağı analizleri için
- SpectraAlyzer GRAIN/Tahıl analizleri için
- SpectraAlyzer TOPWINDOW
- Santrifüjler
- OHAUS FC5816R Santrifüj
- OHAUS FC5816 Santrifüj
- OHAUS FC5718R Santrifüj
- OHAUS FC5306 Santrifüj
- OHAUS FC5718 Santrifüj
- OHAUS FC5707 Santrifüj
- OHAUS FC5706 Santrifüj
- OHAUS FC5515R Santrifüj
- OHAUS FC5515 Santrifüj
- OHAUS FC5513 Santrifüj
- OHAUS FC5714 Santrifüj
- Mikro Santrifüj, Model M1324R
- Mikro Santrifüj | Stuart SCF3
- Mikro Santrifüj | Stuart SCF4
- Neya 8
- Neya 10 ve Neya 10R
- Neya 12 ve Neya 16R
- D1008
- D2012 plus
- D3024
- D1524R
- DM0424
- DM0408
- DM0408
- DM0506
- DM0412
- DM0636
- M 2815 PR REFRIGERATED CENTRIFUGE
- M 2815 P ( FULL SWING-OUT )
- M 19 HAEMATOCRIT CENTRIFUGE
- M 415 P / M 615 P / M 815 / M 4812 P
- M 4815 PR REFRIGERATED CENTRIFUGE
- Erime Noktası Tayin Cihazları
- Stuart SMP50 | Otomatik Erime Noktası Tayin Cihazı
- Stuart SMP30 | Dijital Gelişmiş Erime Noktası Tayin Cihazı
- Stuart SMP10 ve SMP20 | Dijital Erime Noktası Tayin Cihazı
- Stuart SMP11 | Analog Erime Noktası Tayin Cihaz
- Electrothermal IA9000 Serisi | Erime Noktası Tayin Cihazı
- Electrothermal Mel-Temp 1101D
- Karıştırıcılar
- Isıtıcılı Tablalar
- Data Logger
- Ebro SL 3100 Validasyon Seti
- Ebro EBI 10-T100
- Ebro EBI 25-TH
- Ebro EBI 10-TH100
- Ebro EBI 11-TP110
- Ebro EBI 100-T100
- Ebro EBI 40-TC
- Ebro EBI 20-T1
- Ebro EBI 100-T46x
- Ebro SL 3000 Validasyon Seti
- Ebro SL 1520 EBI 16 Bowie and Dick Test Set
- Ebro EBI 25-TX
- Ebro EBI 10-T24x
- Ebro EBI 25-TE
- Ebro EBI 25-T
- Ebro EBI 10-TP200
- Ebro EBI 10-TP451 / 453
- Ebro EBI 10-TP111
- Ebro EBI 10-TP231
- Ebro EBI 10-TP460
- Ebro EBI 10-TP450 / 452
- Ebro EBI 10-TP421
- Ebro EBI 10-TP322
- Ebro EBI 10-TP321
- Ebro EBI 10-TP221
- Ebro EBI 10-TP230
- Ebro EBI 10-T690
- Ozmometreler
- Homojenizatörler
- Koloni Sayıcılar
- Desikatör Kabinleri
- SICCO Star-Desikatör
- SICCO Super-Star-Desikatör
- SICCO Big-Star-Desikatör
- SICCO Maxi 1-Desikatör
- SICCO Star-Vitrum-Desikatör
- SICCO Maxi 2-Vitrum-Desikatör
- SICCO Vacuum 1-Desikatör
- 103-70 Desikatör Kabinleri
- 103-73 Desikatör Kabinleri
- 303-75 Desikatör Kabinleri
- 303-77 Desikatör Kabinleri
- 303-78A Desikatör Kabinleri
- Gıda Kontrol Cihazı
- Spektrofotometreler
- Sonikatörler
- Tüp Çeviriciler
- Elektrikli Bunzen Beki
- Döner Buharlaştırıcılar
- HPLC Kolonları ve Sarfları
- Mantolu Isıtıcılar
- Mikropipetler ve Pipet Uçları
- Şırınga Ucu ve Membrane Filtreler
- Hazır Besiyerleri
- Kromojenik E.Coli / Koliform Agar
- Baird Parker Agar - Staphylococcus Aureus
- Plate Count Agar - Toplam Bakteri Sayımı
- TBX Kromojenik Agar - E. Coli
- VRB Agar (Violet Red Bile Agar)
- VRBG Agar (Enterobacteriaceae)
- DRBC Agar (Küf - Maya Sayımı)
- Kromojenik Salmonella Agar - Salmonella SPP Tespiti
- Kromojenik E.Coli / 0157:H7 Agar
- TSC Agar (Clostridium Perfringens)
- MYP Agar (Bacillus Cereus)
- KF Streptococcal Agar
- Pseudomonas Selective Agar, Base (Cetrimide Agar)
- Listeria Monocytogenes Tespiti
- Sabouraud Dextrose Agar
- Endo Agar
- MacConkey Agar
- Malt Extract Agar
- R2 Agar
- TSA Agar
- EMB Agar
- PDA (Potato Dextrose Agar)
- TBX Chromogenic Agar
- Chromogenic E. Coli / Koliform Agar
- Chromogenic Listeria Agar
- Chromogenic Candida Agar
- Half Fraser Broth ve Fraser Broth
- Bufferred Peptone Water
- Tryptic Soy Agar
- Water Purification Systems - Saf Su Sistemleri
- Özel Soğutucu Dolaplar
- GEA - Valves and Pumps / Vanalar ve Pompalar
- Özel Soğutucu Gıda ve İçeçek Dolapları
- Hava Sterilazyon Cihazları
- Endüstriyel Filtre Grupları
- Monofilament Filtre Torbaları
- PP Polipropilen Sıvı Filtre Torbası
- PTFE (Teflon) Filtre Torbası
- PP Polipropilen Filtre Torbası
- Polyimide P84 Filtre Torbası
- Akrilik Homopolimer Filtre Torbası
- Tavan Filtre
- Cam Elyaf Filtre Torbası
- Meta-Aramid Nomex Filtre Torbası
- Antistatik Filtre Torbası
- Polyester İğneli Keçe Filtre Torbası
- Havalı Oluk Bant Bezi
- Medikal Ürünler
- Molecular Genetic Devices and Consumables
- PRP and CGF Kits
- CRO and Sponsor Pharmaceutical Companies
- Microbiology Kits and Consumables
- Blood Collection Systems
- Sterilization Control Products